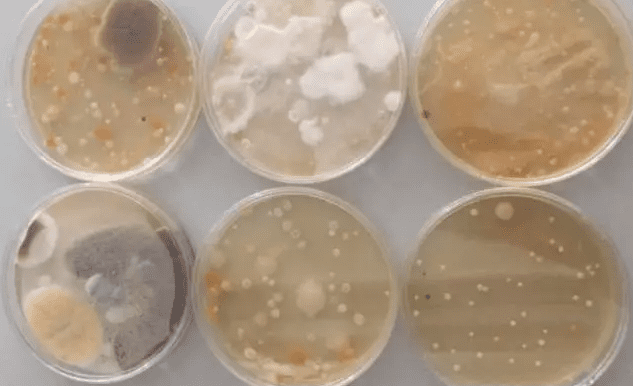

Kitchen And Bath. Kitchen And Bath Headlines.
Recent studies have shown that particles stirred up by men flushing urinals can rise 0.84 meters in 5.5 seconds, and if they carry the virus, they can spread it faster than a toilet flush. During the height of the epidemic in China, research teams have isolated neocoronaviruses in urine samples, and the results of this study raise renewed public health concerns.
Urinals May Transmit The New Coronavirus
In a computer simulation of male urination and urinal flushing published recently in the journal Physics of Fluids, a research team at Yangzhou University found that gas-liquid interactions occur and that particles generated by the flush can form aerosols that are dispersed into the air, with 57% of the particles being splashed.

The study reveals that aerosol particles can rise to 0.84m in 5.5 seconds, equivalent to rising from the ground to the human thigh, while particles from flushing reach 0.93m in 35 seconds, indicating that urinals can spread the virus faster than toilets.
The research team also pointed out that urinals are often used in densely populated areas, which indicates that there is a certain risk of virus transmission in public toilets, and reminded the public to wear masks when using public toilets and to teach them how to use the toilets properly.
In February this year, following the isolation of live neoconaviruses from stool samples by the team of academician Li Lanjuan and Professor Zhao Jincun’s team, Professor Zhao Jincun’s team, an expert from Zhong Nanshan’s team and Deputy Director of the State Key Laboratory of Respiratory Diseases, also isolated neoconaviruses from the urine of patients with neoconavirus pneumonia, revealing the possibility of transmission of the virus through urine.
While a series of findings have raised concerns about public toilets becoming a site of virus transmission, the findings of another study point to the same conclusion. The Assam Sentinel, for one, recently published a study that found that only 4% of a group of quarantined households were infected, as 80% of these people had separate toilets in their homes; on the other hand, the study found that the spread of the virus was much higher in crowded places like army and testing centres, even at 18%, than in homes, because these places did not have separate toilets, only public toilets.
Toilets, Faucets, Showers
There Is Also A Risk Of Poisoning.
Prior to this discovery, experts have warned that there may be ways for the new coronavirus to spread through toilets, faucets, showers or exhaust pipes.
For example, the Southern Medical University biosafety laboratory professor Zhang Qiwei has pointed out that the infected patient after the toilet flush toilet, flush toilet water generally has a greater impact, containing the virus of the feces may be volatile to the air, someone just next to the toilet, it is possible to breathe through the infection. Therefore, experts recommend that the home toilet should be closed after flushing the lid to avoid spreading the water spray or gas with the virus.
Even if it is not a new coronavirus, the toilet flush inspired water spray can also infect other viruses.In 2018, Curious Labs did an experiment, after the toilet flush, randomly extracted the bathroom air samples sent to culture, testing.48 hours later, through the culture out of the results of the observation, air samples in the presence of a large number of Aspergillus niger, Candida albicans, red yeast, hairy mold, Aspergillus flavus and other bacteria.
In addition, Zhang Liubo, chief expert in disinfection at the Chinese Center for Disease Control and Prevention, also previously pointed out on CCTV’s “Focus Interview” program that the faucet button is also a higher risk of transmission. Healthy people who don’t take proper precautions and touch them without washing their hands in time after touching their eyes or mouth are at risk of infection.

Bathroom Cleanliness Is Still The First Line Of Defense
Multiple studies are a reminder that the epidemic is not over and that the focus on personal hygiene and public health should not be put aside. For the time being, good cleaning of the home, especially the bathroom, remains the most effective protective measure. This can be done in the following ways.
– Choose the proper brand of shower products, avoid using inferior quality showerheads. The shower should be maintained regularly, and if the outlet is clogged, it should be cleaned with white vinegar or disinfectant.
– If you have a problem with odor, you should consider replacing the floor drain. If possible, you can choose a floor drain with an automatic sealing core, which effectively avoids the odor problem that occurs when the water seal dries up, and can avoid clogging the drain.
– Exhaust fans need to be cleaned regularly, once every two or three months. Soapy water can be used to scrub the fan blades and body parts to remove oil from the blades, louvers and panels. When cleaning can not use corrosive chemical solutions, or easily damaged plastic parts and outer paint.
– Toilet or squat toilet flush on the surrounding space when there is a certain splash and gas evaporation, it is recommended to flush immediately after the toilet, and at the same time close the toilet cover or squat toilet cover.
– If the conditions allow, you can use the smart toilet. Smart toilet’s automatic lid flip and sensor flush function can reduce contact, avoid cross infection; hip wash function can minimize the residue of feces, avoid dirt stuck to clothing to create secondary pollution; some products equipped with foam shield function, can effectively prevent the spread of viruses into the air, and deodorization function can also curb the smell of the toilet problem.
iVIGA Tap Factory Supplier